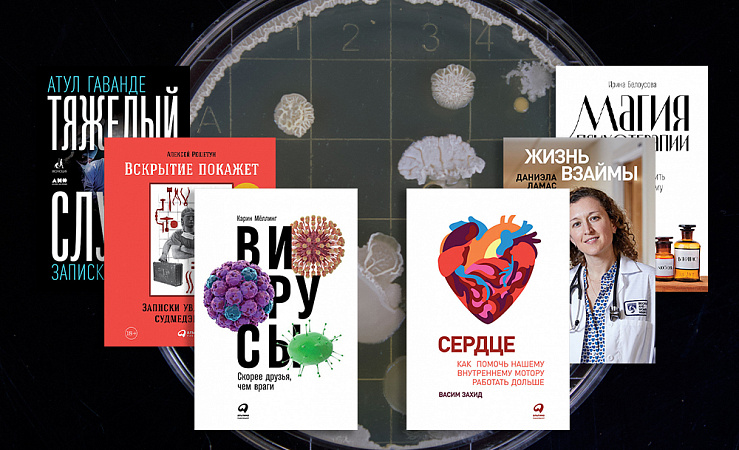
Не гуглится: 6 книг от врачей-практиков Не гуглится: 6 книг от врачей-практиков

Не гуглится: 6 книг от врачей-практиков
Как только у нас появляется какой-то подозрительный кашель или начинает до красноты чесаться рука, мы начинаем гуглить симптомы, хотя знаем — ничем хорошим это не кончится. Собрали шесть книг, которые написали практикующие врачи, чтобы вы лучше поняли свой организм и предотвратили большинство болезней. И чтобы вместо поиска в гугле, сразу записались на приём.
Честные записки судмедэксперта с 16-летним стажем — это яркое напоминание, что все мы смертны и нередко сами сокращаем отведённое нам время. Читатели Алексея Решетуна стремительно бросают курить, выпивать и начинают заниматься спортом. Хотя он вовсе не читает мораль: просто показывает, чем все закончится, если продолжать в том же духе. Его рассказ дополняют фотографии, скрытые под QR-кодами, чтобы не травмировать слишком впечатлительных.
Современная медицина спасает от смерти пациентов, которым 10 лет назад могло помочь разве что чудо. Но что делать, если длительное лечение превращается в бесконечное мучение, — терпеть в ожидании улучшения состояния или махнуть рукой на все усилия врачей? Автор книги, врач реаниматолог, пишет, что жизнь спасенного человека часто меняется навсегда. Это касается как его душевного, так и физического состояния.
Атул Гаванде — практикующий хирург, он ежедневно принимает решения, от которых зависит человеческая жизнь, подчас в ситуациях, когда наука ненадёжна, а информации недостаточно. Автор без прикрас рассказывает о своей практике, о врачебных ошибках и смертях пациентов, о медицинских тайнах, которые не получается разгадать, и о чудесах на хирургическом столе.
Стресс, тревожность, недовольство собой — главные проблемы современного человека. Ирина Белоусова, практикующий психотерапевт и известный блогер, погружает в научную магию психотерапии. Она рассказывает о том, где искать вдохновение; как опознавать уловки мозга и понимать свои чувства; как принимать ситуацию, но вместе с тем ощущать силу и управлять событиями своей жизни.
Мы много говорим о сердце, когда любим, пугаемся, переживаем. Язык придумал много фразеологизмов: «с тяжёлым сердцем», «в сердцах», «предлагать руку и сердце», «как нож в сердце» и много других. Но что мы на самом деле знаем про этот орган? Увлечённый кардиолог Васим Захид написал эту книгу, чтобы мы больше узнали о маленьком моторе, который поддерживает работу нашего тела всю жизнь.
Грипп, ВИЧ, Эбола — мы привыкли думать, что вирусы несут нам только угрозу. Но на самом деле большинство безвредны; более того, они наши незаменимые помощники. Вирусы есть повсюду: в воздухе, растениях и животных, внутри нас самих и даже на нашей коже. Они борются с бактериями, влияют на погоду, наше самочувствие и настроение, способствуют ожирению или лечат от него.
Победить депрессию и научиться жить заново
Убийственные свойства «Прозака» и терапия настроения
«Мёртвых бояться не стоит, опасаться надо живых»
Судмедэксперт о тонкостях работы, отношении к смерти и отличиях от патологоанатома
Как помочь сердцу работать дольше: 5 советов кардиолога
Почти все болезни можно предупредить